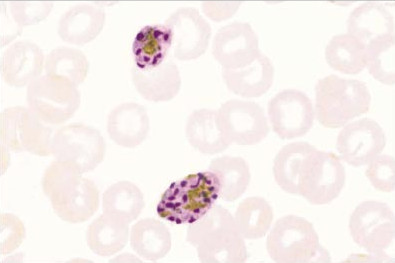
Dimorphic Nature Of Plasmodium Ovale Curitsi And Plasmodium Ovale

Mores.Pics | Update Everything
Find More About "Protein Synthesis Process Transcription Translation Ribosomes Rna"
Explore exclusive offers, detailed information, and related services about protein synthesis process transcription translation ribosomes rna from our trusted partners.
View Special Offers
The Role of Protein in our Bodies - Healthy Essentials Clini...
Source: healthyessentialsclinic.ca

High Protein Foods Vegetarian
Source: www.sweetashoney.co

Chemistry Holistic Health Tip for April: The Importance of P...
Source: spotlightonbusinessmagazine.com

Protein 101 | Back to Basics — tiphandnutrition
Source: static1.squarespace.com

Protein Rich Foods - Top 20 Foods High in Protein | Livofy
Source: www.livofy.com

Complete Protein Combinations Chart for Vegans - Fit Vegan G...
Source: www.fitveganguide.com

Five Things You Should Know About Eating a High-Protein Diet...
Source: www.ualberta.ca

Diagram To Show The Structure Of A Protein Protein Structure
Source: thumbs.dreamstime.com

Printable List of 60 High Protein Foods (FREE Download)
Source: reallifenutritionist.com

High protein diet | Julianne's Paleo & Zone Nutrition
Source: paleozonenutrition.com

Protein - Nutrition Facts Labels Explained by MyFoodDiary
Source: www.myfooddiary.com

What Is Protein?
Source: images.everydayhealth.com

15 High-Protein Vegetables To Boost Your Diet
Source: www.health.com

Protein Foods Pictures
Source: images.immediate.co.uk

Protein in Eggs: What is Protein & How it Benefits You
Source: www.australianeggs.org.au

6 Important Roles of Protein — Get Your Lean On
Source: getyourleanon.com

Protein: Definition, Function, and Sources - Regal Springs I...
Source: regalsprings.co.id

Introduction To Protein And High Protein Foods - Unlock Food
Source: www.unlockfood.ca

Protein Food Sources
Source: c8.alamy.com

Top 21 Protein Rich Foods to Lose Weight - Fitterfly
Source: www.fitterfly.com

How to increase metabolism and lose weight | HealthShots
Source: images.healthshots.com

Vegetables With Protein
Source: www.thespruceeats.com

Protein Rich Food
Source: m.recipes.timesofindia.com

10 Best Lean Protein Foods List - Diets Meal Plan
Source: www.dietsmealplan.com

List Of High Protein Foods (Plus Printable Sheet) No
Source: www.nogettingoffthistrain.com

Your Protein Intake Matters. This Visual Guide Shows How Muc...
Source: www.cnet.com

Sources Of Proteins
Source: plantbasednews.org

High Protein Foods List, Best Protein, Healthy Protein, High...
Source: i.pinimg.com

15 Protein Rich Foods You Should Consider Eating Often | Thr...
Source: www.thrivenaija.com

What is protein? | Live Science
Source: cdn.mos.cms.futurecdn.net

Protein
Source: kaynutrition.com

The Best Sources of Protein to Add to Your Diet | Best Healt...
Source: www.besthealthmag.ca

Protein: What It Is, Types, Uses, Needs, Deficiency
Source: www.verywellhealth.com

The Power of Protein
Source: www.culturalhealthsolutions.com